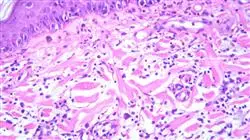
##IMAGE##

Universitäre Qualifikation
Die größte Fakultät für Medizin der Welt"
Präsentation
Bringen Sie Ihr Wissen durch den Universitätskurs in Aktualisierung in Dermatologischer Pathologie: Konnektivopathologien praxisnah und auf Ihre Bedürfnisse abgestimmt auf den neuesten Stand“

Bindegewebserkrankungen sind eine heterogene Gruppe systemischer Entzündungskrankheiten mit autoimmuner Ätiologie, darunter Lupus erythematodes, Sklerodermie, Dermatomyositis oder gemischte Bindegewebserkrankungen, mit variablen Symptomen und Anzeichen, die gleichzeitig oder schleichend im Laufe von Wochen oder Monaten auftreten können.
In vielen Fällen kann die Hautbeeinträchtigung sehr behindernd sein und die Lebensqualität der Patienten deutlich verschlechtern. Aus diesem Grund muss der Arzt über die modernsten Instrumente und Kenntnisse verfügen, um die geeignete Therapie je nach den Bedürfnissen des Patienten und der Etymologie der Krankheit anzuwenden.
Dieser Universitätskurs soll den Arzt in Bezug auf die wichtigsten Bindegewebserkrankungen auf den neuesten Stand bringen, was zweifellos bei der Entscheidungsfindung zur Verbesserung der Behandlung und Prognose der Patienten helfen wird. Es handelt sich um eine Aktualisierung der Kenntnisse und Fähigkeiten nach den neuesten wissenschaftlichen Erkenntnissen, die sich in theoretischem und praktischem Material widerspiegeln, das von den erfahrensten Lehrkräften entwickelt wurde.
Der Student kann flexibel wählen, wo, wie und wann er von seiner virtuellen Plattform aus 24 Stunden am Tag lernen möchte. Es handelt sich um einen 6-wöchigen Studiengang mit einem umfassenden Lehrplan, der Videos, Zusammenfassungen, Bilder, Diagramme, Tests und Wiederholungstests, Kurzanleitungen, ergänzende Lektüre und vieles mehr umfasst. All dies ist von jedem Gerät mit Internetanschluss aus zugänglich.
Darüber hinaus wird den Studenten die Möglichkeit geboten, an einer zusätzlichen exklusiven Masterclass teilzunehmen, die von einem renommierten internationalen Experten für Dermatologie gehalten wird. Auf diese Weise begleitet der Spezialist die Studenten bei der Stärkung ihrer Fähigkeiten und der Aneignung von Kenntnissen, die für eine herausragende Tätigkeit in diesem speziellen Bereich erforderlich sind.
Sie nehmen an einer exklusiven Masterclass teil, die von einem führenden internationalen Dozenten mit Spezialisierung auf Dermatologie geleitet wird. Und das alles unter Einhaltung der Qualitätsstandards, für die TECH bekannt ist!"
Dieser Universitätskurs in Aktualisierung in Dermatologischer Pathologie: Bindegewebserkrankungen enthält das vollständigste und aktuellste wissenschaftliche Programm auf dem Markt. Seine herausragendsten Merkmale sind:
- Die Entwicklung praktischer Fälle, die von Experten der Dermatologie vorgestellt werden
- Der anschauliche, schematische und äußerst praxisnahe Inhalt vermittelt alle für die berufliche Praxis unverzichtbaren wissenschaftlichen und praktischen Informationen
- Er enthält praktische Übungen, in denen der Selbstbewertungsprozess durchgeführt werden kann, um das Lernen zu verbessern
- Sein besonderer Schwerpunkt liegt auf innovativen Methoden
- Theoretische Lektionen, Fragen an den Experten, Diskussionsforen zu kontroversen Themen und individuelle Reflexionsarbeit
- Die Verfügbarkeit des Zugriffs auf die Inhalte von jedem festen oder tragbaren Gerät mit Internetanschluss
Dank dieses Programms werden Sie die Unterschiede zwischen den verschiedenen Arten von Bindegewebserkrankungen feststellen, indem Sie die wichtigsten klinischen Erscheinungsformen analysieren"
Zu den Dozenten des Programms gehören Fachkräfte aus der Branche, die ihre Erfahrungen in diese Fortbildung einbringen, sowie anerkannte Spezialisten von führenden Gesellschaften und renommierten Universitäten.
Die multimedialen Inhalte, die mit der neuesten Bildungstechnologie entwickelt wurden, werden der Fachkraft ein situiertes und kontextbezogenes Lernen ermöglichen, d. h. eine simulierte Umgebung, die eine immersive Fortbildung bietet, die auf die Ausführung von realen Situationen ausgerichtet ist.
Das Konzept dieses Programms konzentriert sich auf problemorientiertes Lernen, bei dem die Fachkraft versuchen muss, die verschiedenen Situationen aus der beruflichen Praxis zu lösen, die während des gesamten Studiengangs gestellt werden. Zu diesem Zweck wird sie von einem innovativen interaktiven Videosystem unterstützt, das von renommierten Experten entwickelt wurde.
Dank dieses Programms werden Sie die Unterschiede zwischen den verschiedenen Arten von Bindegewebserkrankungen feststellen, indem Sie die wichtigsten klinischen Erscheinungsformen analysieren"

Sie werden mehr über die wichtigsten Verhornungsstörungen und ihre unterschiedlichen Merkmale erfahren"
Lehrplan
Das 100%ige Online-Studiensystem von Universitätskurs bietet dem Spezialisten, der sich über die neuesten Fortschritte und modernsten klinischen Verfahren auf dem Laufenden halten möchte, zahlreiche Vorteile. Von einem bequemen digitalen Gerät mit Internetanschluss aus kann er diese Fortbildung problemlos absolvieren. Darüber hinaus kann er selbst entscheiden, wann er am besten vorankommt, da die Inhalte des Universitätskurses 24 Stunden am Tag zum Nachschlagen oder Herunterladen zur Verfügung stehen, was eine größere Organisationsfreiheit ermöglicht.

Mit diesem Programm steht Ihnen der umfassendste Lehrplan für Bindegewebserkrankungen und Autoimmunerkrankungen zur Verfügung“
Modul 1. Bindegewebserkrankungen und Autoimmunkrankheiten
1.1. Haut und Bindegewebe
1.2. Rheumatoide Arthritis
1.3. Systemischer Lupus erythematodes
1.4. Sklerodermie
1.5. Dermatomyositis
1.6. Sjögren-Syndrom
1.7. Ehlers-Danlos-Syndrom
Dieser Universitätskurs in Bindegewebserkrankungen enthält das vollständigste und aktuellste wissenschaftliche Programm auf dem Markt und Sie können es zu 100% online studieren“
Universitätskurs in Dermatologischer Pathologie: Bindegewebserkrankungen
Bindegewebserkrankungen sind eine Gruppe von Autoimmunerkrankungen, die in erster Linie das Bindegewebe des Körpers, einschließlich der Haut, betreffen. Das Verständnis und die richtige Behandlung dieser Pathologien ist für Dermatologen unerlässlich. In unserem Universitätskurs in Dermatologischer Pathologie konzentrieren wir uns auf Bindegewebserkrankungen und vermitteln den Teilnehmern das notwendige Wissen für die Diagnose und Behandlung dieser Erkrankungen.
Dieser Universitätskurs bietet einen umfassenden Überblick über die häufigsten Bindegewebserkrankungen, darunter systemischer Lupus erythematodes, Sklerodermie und Dermatomyositis. Die Teilnehmer erfahren etwas über die Diagnosekriterien, die charakteristischen Hauterscheinungen und die Behandlungsmöglichkeiten für jede Krankheit. Darüber hinaus werden Themen wie die Pathophysiologie von Bindegewebserkrankungen, die bei der Diagnose verwendeten Labortests und die neueste Forschung auf diesem Gebiet behandelt.







